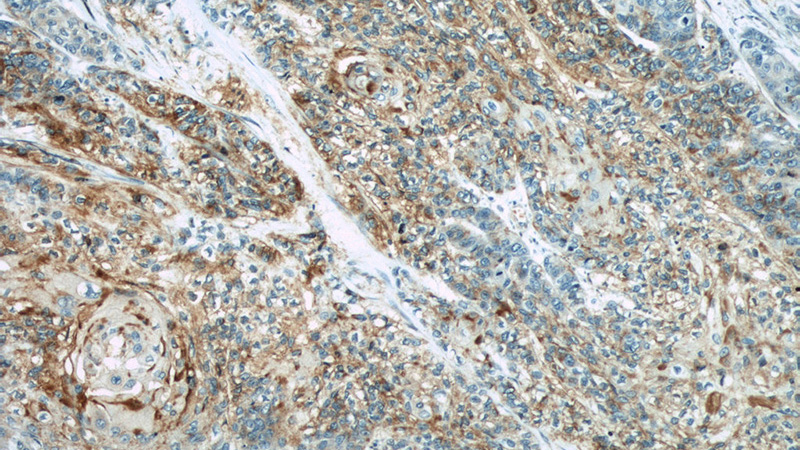
Immunohistochemical of paraffin-embedded human oesophagus cancer using Catalog No:109235(CHMP4B antibody) at dilution of 1:50 (under 10x lens)
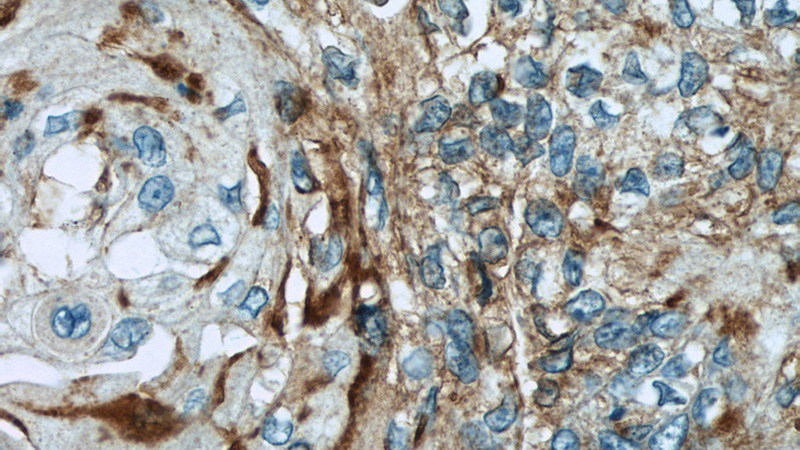
Immunohistochemical of paraffin-embedded human oesophagus cancer using Catalog No:109235(CHMP4B antibody) at dilution of 1:50 (under 40x lens)

-
Product Name
CHMP4B antibody
- Documents
-
Description
CHMP4B Rabbit Polyclonal antibody. Positive WB detected in mouse heart tissue, HeLa cells, rat heart tissue, transfected cells. Positive IHC detected in human oesophagus cancer tissue, human heart tissue, human skeletal muscle tissue. Observed molecular weight by Western-blot: 29-33 kDa
-
Tested applications
ELISA, WB, IHC
-
Species reactivity
Human, Mouse, Rat; other species not tested.
-
Alternative names
C20orf178 antibody; CHMP4B antibody; chromatin modifying protein 4B antibody; CTPP3 antibody; dJ553F4.4 antibody; hSnf7 2 antibody; hVps32 2 antibody; Shax1 antibody; SNF7 antibody; SNF7 2 antibody; Vps32 2 antibody
-
Isotype
Rabbit IgG
-
Preparation
This antibody was obtained by immunization of CHMP4B recombinant protein (Accession Number: NM_176812). Purification method: Antigen affinity purified.
-
Clonality
Polyclonal
-
Formulation
PBS with 0.1% sodium azide and 50% glycerol pH 7.3.
-
Storage instructions
Store at -20℃. DO NOT ALIQUOT
-
Applications
Recommended Dilution:
WB: 1:200-1:1000
IHC: 1:20-1:200
-
Validations

WB result of anti-CHMP4B (Catalog No:109235) with “in vitro translated MYC-CHMP4B in wheatgerm lysates”.

mouse heart tissue were subjected to SDS PAGE followed by western blot with Catalog No:109235(CHMP4B antibody) at dilution of 1:200
Immunohistochemical of paraffin-embedded human oesophagus cancer using Catalog No:109235(CHMP4B antibody) at dilution of 1:50 (under 10x lens)
Immunohistochemical of paraffin-embedded human oesophagus cancer using Catalog No:109235(CHMP4B antibody) at dilution of 1:50 (under 40x lens)
-
Background
CHMP4B (charged multivesicular body protein 4b) is a human homologue of yeast Snf7p (also named Vps32p) and a member of CHMP family which is implicated in multivesicular body (MVB) sorting. The CHMP proteins are components of ESCRT-III (endosomal sorting complex required for transport III), a complex involved in degradation of surface receptor proteins and formation of endocytic multivesicular bodies. Among seven CHMP family members, only CHMP4 has been found to interact with Alix, a multifunctional adaptor protein in various cellular functions. This antibody is highly specific to the CHMP4B and it doesn’t cross-react with other CHMPs as well as other CHMP4s (CHMP4A and CHMP4C).
-
References
- Flores-Rodriguez N, Kenwright DA, Chung PH. ESCRT-0 marks an APPL1-independent transit route for EGFR between the cell surface and the EEA1-positive early endosome. Journal of cell science. 128(4):755-67. 2015.
- Ali N, Zhang L, Taylor S, Mironov A, Urbé S, Woodman P. Recruitment of UBPY and ESCRT exchange drive HD-PTP-dependent sorting of EGFR to the MVB. Current biology : CB. 23(6):453-61. 2013.
Related Products / Services
Please note: All products are "FOR RESEARCH USE ONLY AND ARE NOT INTENDED FOR DIAGNOSTIC OR THERAPEUTIC USE"
